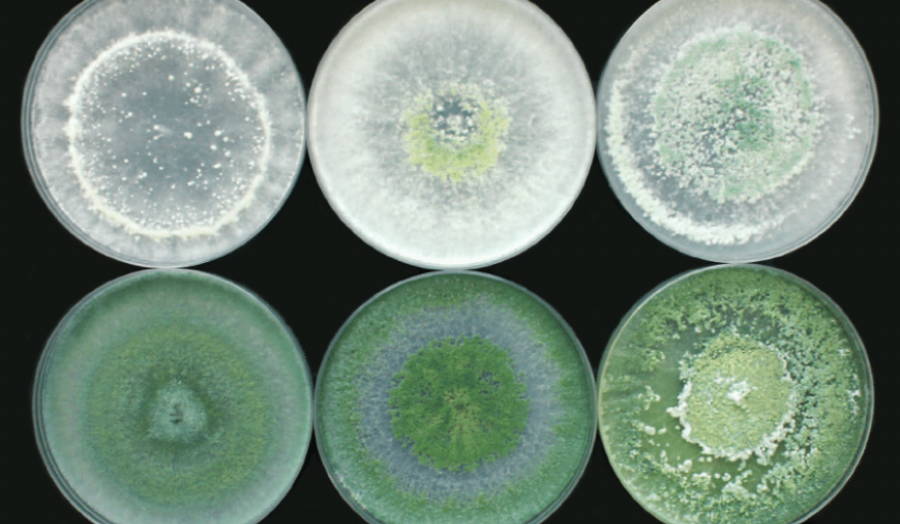

Un equipo de investigación liderado por la docente de la UNTDF e investigadora del CONICET, Paulina Moya, desarrolló Tricho DF, un bioinsumo formulado a partir de cepas locales del hongo Trichoderma, adaptadas a las bajas temperaturas de Tierra del Fuego. El hallazgo podría marcar un antes y un después en la agricultura local, al mejorar el rendimiento de cultivos como la lechuga y actuar como defensa natural frente a enfermedades como la podredumbre gris.
El proyecto lleva cinco años de trabajo, durante los cuales se realizaron aislamientos de suelos en huertas fueguinas hasta identificar dos cepas capaces de sobrevivir y desarrollarse en condiciones extremas, algo poco frecuente en este tipo de microorganismos.
Los ensayos iniciales, realizados en colaboración con el INTA en Ushuaia y Río Grande, arrojaron resultados positivos: aumento del crecimiento de las plantas y reducción significativa del impacto de la podredumbre gris, enfermedad que también afecta a cultivos de frutilla presentes en la provincia.
Además de su función como biofertilizante, el Trichoderma fueguino actúa como biocontrolador natural, compitiendo con hongos patógenos y generando metabolitos beneficiosos para el desarrollo vegetal. “Es como un hongo protector”, resumió Moya.
Actualmente, el equipo busca financiamiento para instalar una biofábrica piloto que permita producir Tricho DF a escala y abastecer a productores locales. “La clave está en que estas cepas son fueguinas y están adaptadas al clima local, algo que no logran los hongos traídos de otras regiones”, explicó la investigadora.
Si bien por ahora el desarrollo se probó en lechuga, se proyecta su aplicación en frutilla, tomate y otros cultivos locales, con el objetivo de ampliar el uso de bioinsumos adaptados a las condiciones de Tierra del Fuego y fortalecer la soberanía alimentaria en la región.
Compartinos tu opinión